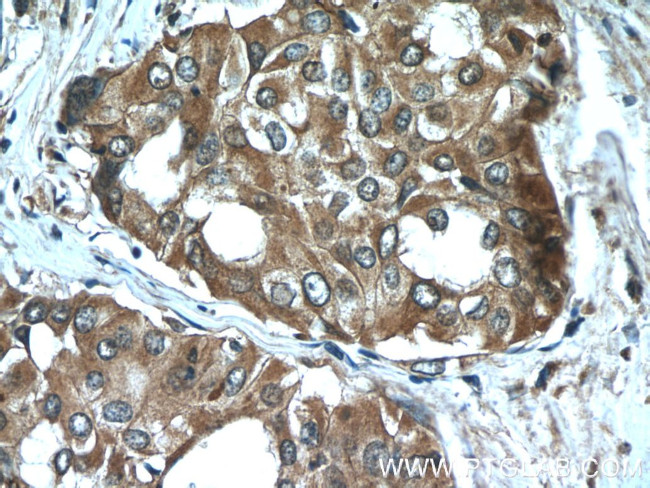
Sodium Iodide Symporter Antibody in Immunohistochemistry (Paraffin) (IHC (P))

Search
Proteintech
Sodium Iodide Symporter Polyclonal Antibody
{{$productOrderCtrl.translations['antibody.pdp.commerceCard.promotion.promotions']}}
{{$productOrderCtrl.translations['antibody.pdp.commerceCard.promotion.viewpromo']}}
{{$productOrderCtrl.translations['antibody.pdp.commerceCard.promotion.promocode']}}: {{promo.promoCode}} {{promo.promoTitle}} {{promo.promoDescription}}. {{$productOrderCtrl.translations['antibody.pdp.commerceCard.promotion.learnmore']}}
产品信息
24324-1-AP
种属反应
已发表种属
宿主/亚型
分类
类型
抗原
偶联物
形式
浓度
规格
纯化类型
保存液
内含物
保存条件
运输条件
产品详细信息
This antibody recognizes the mature approximately 75-100 kDa protein and a partially glycosylated 50-55 kDa protein.
Immunogen sequence: TVLCGALIS CLTGPTKRST LAPGLLWWDL ARQTASVAPK EEVAILDDNL VKGPEELPTG NKKPPGFLPT NEDRLFFLGQ KELEGAGSWT PCVGHDGGRD QQETNL (539-643 aa encoded by BC105047)
靶标信息
Human Sodium Iodide Symporter (hNIS) is responsible for iodide concentrating ability within thyroid follicular cells. It is a membrane bound glycoprotein with 13 membrane spanning domains and 14 extramembranous domains. It may represent an autoantigen in thyroid.
仅用于科研。不用于诊断过程。未经明确授权不得转售。
生物信息学
蛋白别名: Na(+)/I(-) cotransporter; Na(+)/I(-) symporter; Na(+)/I(-)-symporter; Na+/I- symporter; Natrium iodide transporter; Sodium-iodide symporter; Sodium/iodide cotransporter; solute carrier family 5 (sodium iodide symporter), member 5; solute carrier family 5 (sodium/iodide cotransporter), member 5; Solute carrier family 5 member 5; solute carrier family 5, member 5
基因别名: NIS; SLC5A5; TDH1
UniProt ID: (Human) Q92911, (Rat) Q63008
Entrez Gene ID: (Human) 6528, (Rat) 114613, (Mouse) 114479